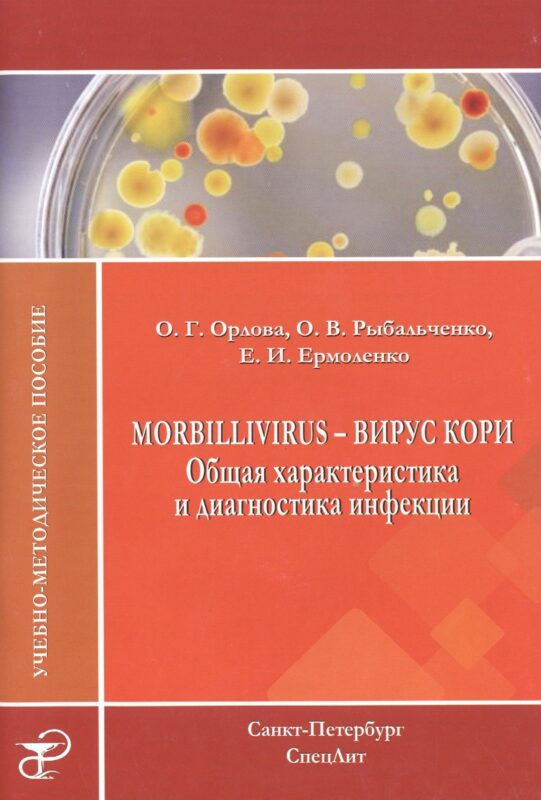
Morbillivirus - вирус кори. Общая характеристика и диагностика инфекции: учебно-методическое пособие

Чтобы обеспечить максимально удобную работу с сайтом, мы используем такие технологии, как файлы cookie, для хранения информации о вашем устройстве и/или доступа к ней. Согласие на использование этих технологий позволит нам обрабатывать такие данные, как история просмотров или уникальные идентификаторы на этом сайте. Отказ от согласия или его отзыв может отрицательно сказаться на работе определенных функций и возможностей сайта.
Техническое хранение или доступ строго необходимы для законной цели предоставления конкретной услуги, запрошенной пользователем, или исключительно для передачи сообщения по сети электронных коммуникаций.
Техническое хранение или доступ необходимы для законной цели хранения настроек, не запрошенных пользователем.
Техническое хранение или доступ, которые используются исключительно в статистических целях.
Техническое хранение или доступ, используемые исключительно в анонимных статистических целях. Без официального запроса, добровольного согласия вашего интернет-провайдера или дополнительных записей третьих лиц, информация, хранящаяся или извлекаемая только для этой цели, обычно не может быть использована для вашей идентификации.
Техническое хранение или доступ требуются для создания профилей пользователей с целью рассылки рекламы или отслеживания пользователя на одном или нескольких веб-сайтах в маркетинговых целях.


 Доставка 7-28 раб.дней
Доставка 7-28 раб.дней